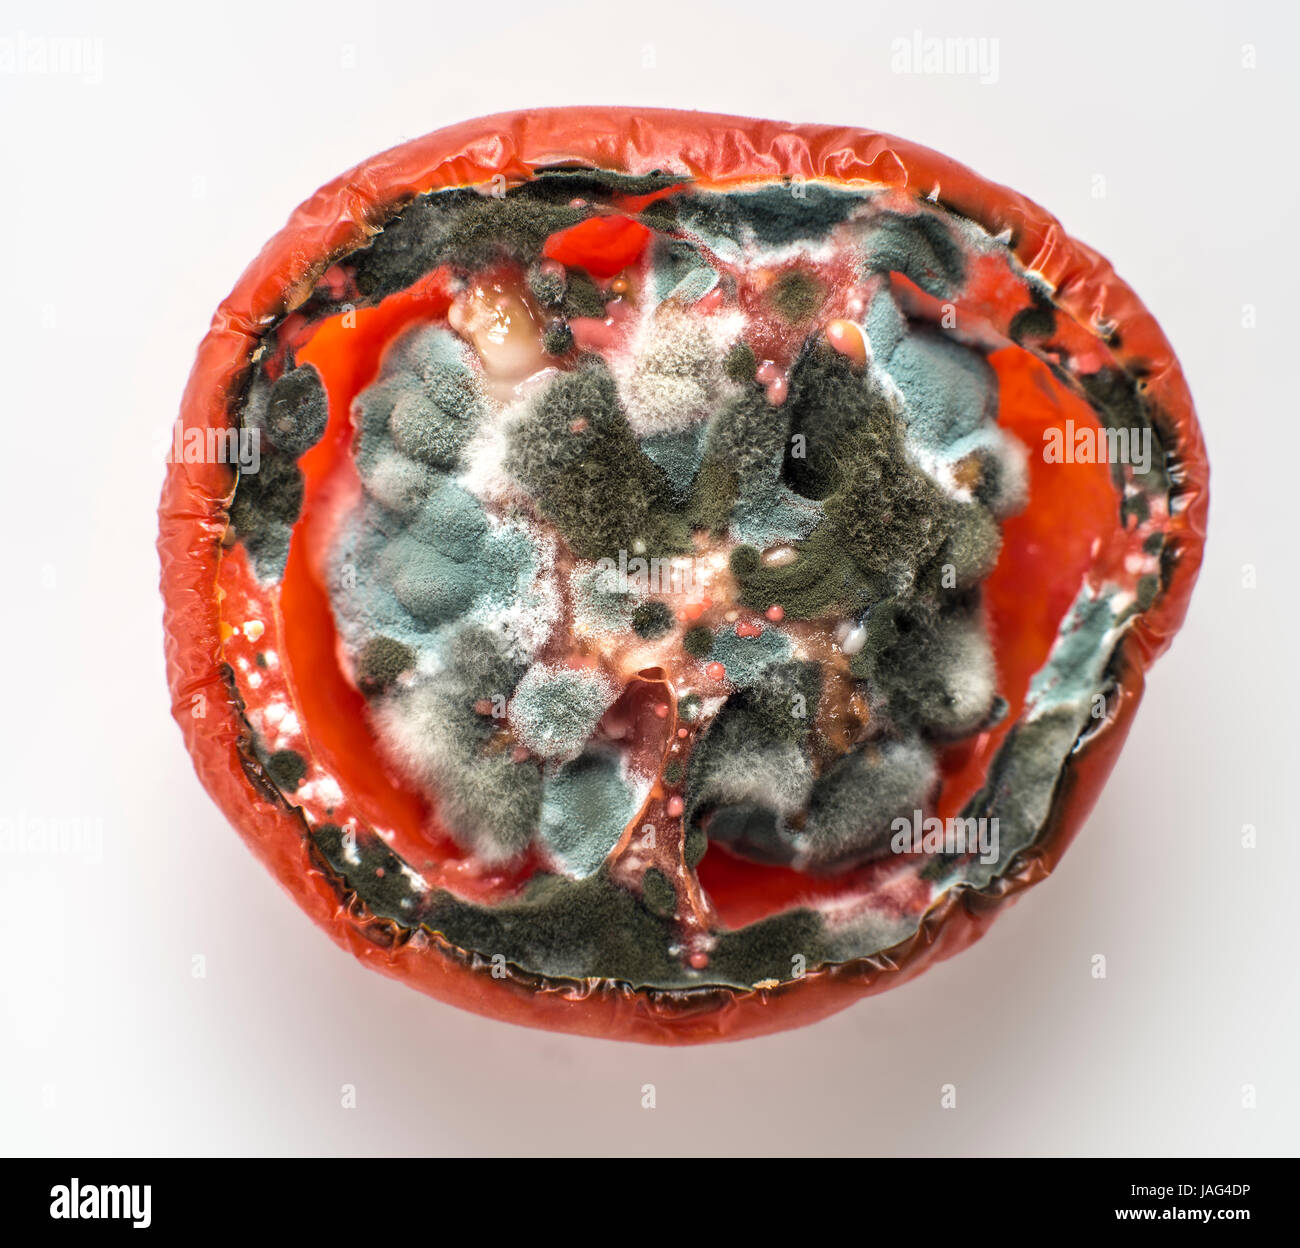
Faule Tomaten Stockfoto

Schnellfilter:
Rotten tomato Stockfotos & Bilder

RF2K46CP1–Verfaulte Tomaten. Schimmel auf Gemüse. Verfaultes Produkt.fehlendes Gemüse isoliert auf weißem Hintergrund

RM2RT7B7G–Eine Gruppe weiblicher Essigeinfliegen, Drosophila immigrans, die sich vom Fleisch einer verfaulten Tomate in einem britischen Garten ernähren

RF2K1M2H7–Tomate in einem Gewächshaus beschädigt durch Schädlinge und Krankheiten. Loch in einer reifenden Tomate.

RF2K46CM2–Verfaulte Tomaten. Schimmel auf Gemüse. Verfaultes Produkt.fehlendes Gemüse isoliert auf weißem Hintergrund

RF2JF5J8J–Verfaulte Tomate zerdrückt und mit einigen Fliegen über zersetztem Saft geschnitten, isoliert auf weißem Hintergrund.

RF2PFJNDH–Einige faule Tomaten und einige unberührte Tomaten befinden sich in einem durchsichtigen Plastikbeutel auf einer weißen Küchenarbeitsfläche.

RF2G4G4R1–Gesunde und verfaulte Früchte in einem Förderband. Verfaulte Früchte von gesunden Früchten getrennt. Drei Gemüse: Tomate, Orange, grüne Zitrone.

RF2A7189A–Eine verfaulte Tomate im Fokus auf der rechten Seite, drei Unscharf im Hintergrund, alle auf Weiß isoliert

RF2K46CP6–Verfaulte Tomaten. Schimmel auf Gemüse. Verfaultes Produkt.fehlendes Gemüse isoliert auf weißem Hintergrund

RF2JF5J87–Isolierte faule Tomate mit Stiel, der übel riechenden Saft vergiesst. Design im Cartoon-Stil auf weißem Hintergrund.

RF2PFJN4W–Einige faule Tomaten und einige unberührte Tomaten befinden sich in einem durchsichtigen Plastikbeutel auf einer weißen Küchenarbeitsfläche.

RF2KFHEMM–Verfaulte Tomaten. Verfaultes Produkt. Das Essen war verdorben. Faules Gemüse. Zerbrochene Tomatenoberfläche. Fliegen sitzen auf einem verfaulten Gemüse

RF2K46CP0–Verfaulte Tomaten. Schimmel auf Gemüse. Verfaultes Produkt.fehlendes Gemüse isoliert auf weißem Hintergrund

RF2K55ARD–Verfaulte Tomaten Haufen Schimmel Pilze Bauernhof Landwirtschaft Abfall bio verworfen organisch Fäule Rost Gemüse Pflanze schimmelig Anbau muffig rostig Gewächshaus Moos Detail

RF2YFAG3P–Ein Stück verfaultes, ungesundes rotes Tomatengemüse, isoliert auf magentafarbenem Hintergrund